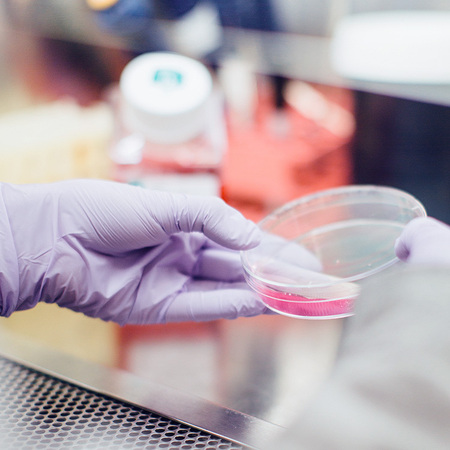
upload/20231115100212884.jpg

Ukapu 教育 —— 定制化语言学习与国际视野拓展专家 一、核心课程体系:个性化语言学习方案 Ukapu 教育专注于提供高质量的线上语言课程,满足不同学员的学习需求,具体包括: 1 对 1 定制课程:根据学员的年龄、基础、学习目标(如日常交流、考试冲刺、留学准备等)量身设计教学内容,进度灵活,针对性极强。
20w+
海外优秀留学生50+
留学教育经验300+
专业教师团队150+
专业课程现有一级学科国家学科11个,二级学科国家学科19个,国家学科覆盖的二级学科博士点占全校博士点总数的61.8%;有15个学科领域进入ESI全球前1%,数量位居全国第二理工科,临床医学也初步具备冲击世界优异学科的实力。

古典文献学

国际经济与贸易

人力资源管理

视觉传达设计

网络与新媒体
生物医学工程

学校拟在广东招录150余名本科生,若未被该校录取,不影响本科批次的录取。将于6月中旬参加学校组织的自主能力测试(含面试)。我们在今年将会加大对优秀学子的奖励和资助力度。今年学校计划全额资助高考成绩在全省理科排名前200名。
近期,在一些短视频平台,时不时会刷到这样“惊悚”的一幕:镜头扫过一个房间,桌子上摆放着数十台电脑,屏幕上的主播正实时在线直播卖货,配文却赫然写着:“太吓人了,200平方米直播基地空无一人,全是AI数字人直播。”
今年2月,上海市政府正式发布《推进“大零号湾”科技创新策源功能区建设方案》,借上海市政府推进“大零号湾”创新策源地建设契机,今年闵行科技节将围绕“科创策源,智创未来”主题开展活动
央广网北京5月23日报道,据中国载人航天工程办公室消息,神舟十六号载人飞船与长征二号F遥十六运载火箭组合体22日转运至发射区,计划近日择机实施发射。
湖北省市场监督管理局党组成员陈专在致辞中提到,发展食品科学,促进食品产业健康发展,是落实健康中国战略,满足人民群众对美好生活追求的一件大事